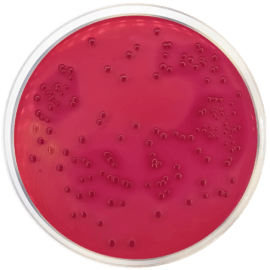
main product photo

Close
DESOXYCHOLATE LACTOSE AGAR 500 grams/bottle
SKU
CDL/1025
Brand
CONDALAB
Pre-order (Deliver in 8 to 12 weeks)
Desoxycholate Lactose Agar is a differential and slightly selective medium for the isolation of gram-negative enteric bacilli. It is used to isolate and enumerate coliforms from water, wastewater, milk and dairy products.
The desoxycholate and citrate salts inhibit the development of gram-positive organisms. The Bacteriological peptone provides nitrogen, vitamins, minerals and amino acids essential for growth. Lactose is the fermentable carbohydrate providing carbon and energy. Sodium chloride supplies essential electrolytes for transport and osmotic balance. Neutral red is a pH indicator. Bacteriological agar is the solidifying agent.
In general, it is used for the enumeration of coliforms by the dilution method. This is accomplished by adding 1 ml of the desired dilution to an empty Petri dish and pouring it on the cooled (45-50 °C) medium. If the product to be tested has not been diluted (e.g. pasteurized milk), it can be added directly to the melted medium and poured plates. It is convenient to put a second layer of medium on the plate after initial solidification.
Coliform colonies are lenticular, pink or bright red. Differentiation is made on the basis of the lactose fermentation: lactose fermenters in the presence of neutral red give red colonies while non-fermenters give colorless colonies (Salmonella and Shigella). If no second layer is applied, the colonies of Escherichia coli which develop on the surface of the plate are large and pink while Enterobacter aerogenes are pale with a pink center.
Desoxycholate Lactose Agar is a differential and slightly selective medium for the isolation of gram-negative enteric bacilli. It is used to isolate and enumerate coliforms from water, wastewater, milk and dairy products.
The desoxycholate and citrate salts inhibit the development of gram-positive organisms. The Bacteriological peptone provides nitrogen, vitamins, minerals and amino acids essential for growth. Lactose is the fermentable carbohydrate providing carbon and energy. Sodium chloride supplies essential electrolytes for transport and osmotic balance. Neutral red is a pH indicator. Bacteriological agar is the solidifying agent.
In general, it is used for the enumeration of coliforms by the dilution method. This is accomplished by adding 1 ml of the desired dilution to an empty Petri dish and pouring it on the cooled (45-50 °C) medium. If the product to be tested has not been diluted (e.g. pasteurized milk), it can be added directly to the melted medium and poured plates. It is convenient to put a second layer of medium on the plate after initial solidification.
Coliform colonies are lenticular, pink or bright red. Differentiation is made on the basis of the lactose fermentation: lactose fermenters in the presence of neutral red give red colonies while non-fermenters give colorless colonies (Salmonella and Shigella). If no second layer is applied, the colonies of Escherichia coli which develop on the surface of the plate are large and pink while Enterobacter aerogenes are pale with a pink center.
| Brand | CONDALAB |
|---|
Write Your Own Review

Validate your login